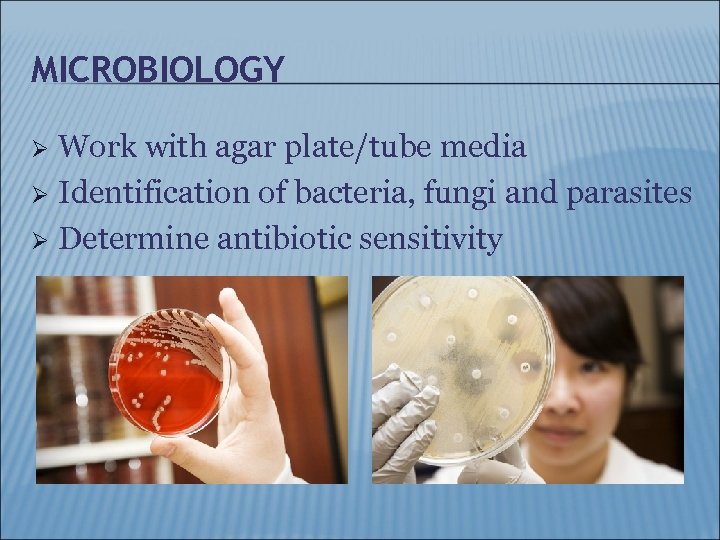
MICROBIOLOGY Work with agar plate/tube media Ø Identification of bacteria, fungi and parasites Ø

ba32a1c2907f2d2844be64e3b1bf5b04.ppt
- Количество слайдов: 29

CLINICAL LABORATORY CAREERS Developed by: Teresa Nguyen, B. S. Brian Chen, B. S. Heritage University Yakima Regional CLS Program 2009

SOMETHING TO THINK ABOUT What is your body going through when you get sick? Ø Where does your blood go after it is drawn? Ø How do doctors come up with their diagnoses? Ø

QUICK FACTS Ø The laboratory team assists in Ø Determining presence and absence of disease/abnormalities within the body Evaluating the effectiveness of treatments 80% of all physician decisions are based on lab test results

THE LABORATORY Are you looking for a career where you can help others in the healthcare field without being a doctor or nurse? Ø A career in clinical laboratory science offers: Ø Many benefits Lots of job opportunities Room for advancement Job security

DEPARTMENTS IN LABORATORY Blood Banking Ø Chemistry Ø Hematology/Coagulation Ø Urinalysis Ø Microbiology Ø

BLOOD BANKING Ø Ø Determine Blood types – ABO and Rh typing Prepare blood and components for transfusions Antibody screening Antibody identification

CHEMISTRY Ø Ø Chemical testing on blood and urine Some examples of testing include: Cholesterol Electrolytes Enzymes Hormones Vitamins Blood Glucose Drug Concentrations

CHEMISTRY Ø Additional testing Detect antibody production to diseases/infections • • • Allergies Hepatitis HIV Herpes Many more… Molecular diagnostics such as PCR Blood gas analysis

HEMATOLOGY Ø Microscopic Examination of: Ø Red blood cells White Blood Cells Platelets Look for anemia, leukemia, and other abnormalities

HEMATOLOGY Automated blood cell counts Ø Coagulation Ø Test ability of blood to clot Give results for drug therapy • • Heparin Coumadin

URINALYSIS Ø Analysis of urine for elements such as Glucose Protein Blood Ketones Bilirubin p. H Crystals Bacteria
MICROBIOLOGY Work with agar plate/tube media Ø Identification of bacteria, fungi and parasites Ø Determine antibiotic sensitivity Ø

SKILLS REQUIRED Ø Ø Ø Ø Aptitude for science course work Good hand/eye coordination and manual dexterity Good communication skills Detail orientated Organized and able to multitask Works well under pressure Ability to work as a team player Desire to help others

PLACES OF EMPLOYMENT Ø Ø Ø Ø Hospitals Clinics Research facilities Industries Universities Government Veterinary/zoos Ø Ø Ø Public health Reference labs Forensics Law Other health related agencies And many more…

AVAILABLE CAREERS IN THE LABORATORY Clinical Laboratory Scientist/Medical Technologist (CLS/MT) Ø Clinical Laboratory Technician/Medical Technician (CLT/MLT) Ø Pathologist (MD) Ø Pathologist Assistant (PA) Ø Cytotechnologist (CT) Ø Histotechnologist (HTL) Ø Histotechnician (HT) Ø Phlebotomist Ø

CLS/MT Ø Ø Ø Bachelors Degree One year training in an accredited education program ASCP (MT) or NCA (CLS) certification Performs laboratory testing on blood, urine, feces, spinal fluid and other body fluids Uses microscopes and operates complex automated instruments Assists physicians and pathologists in diagnosis of disease

CLT/MLT Ø Ø Two year Associates Degree program ASCP (MLT) or NCA (CLT) certification exam Ø Performs laboratory testing under supervision of CLS/MT

PATHOLOGIST/PATHOLOGY ASSISTANT Ø Pathologist Ø Bachelors degree + Medical Doctorate degree + 3 -8 year internship/residency A physician who studies and examines body fluids, tissues and cells Perform autopsies Pathology Assistant Bachelors degree + 2 year pathology assistant program AAPA exam/Masters degree Assist pathologist in their duties

CYTOTECHNOLOGIST Bachelors degree + CT (ASCP) exam Ø One Year Cytotechnology program Ø Examines and identifies abnormal cells Ø Screening of PAP smears and other body fluids Ø

HISTOLOGIST/HISTOTECHNICIAN Ø Histotechnician Ø Associates degree + HT (ASCP) exam Prepares microscope slides from solid tissues from biopsy samples for examination under microscope Histologist Bachelors degree + HTL (ASCP) exam Studies tissue samples

PHLEBOTOMIST Trained to draw blood from patients for laboratory testing Ø Specialized 3 -6 month training program Ø

JOB OUTLOOK Employment is expected to grow 14% between 2006 and 2016 Ø In 2006, clinical laboratory technologist and technicians held 319, 000 jobs in the U. S. Ø WA State Salary estimates Ø CLS/MT: $43, 260 -$58, 250 CLT/MLT: $25, 900 -$35, 400 http: //www. bls. gov/ocos 096. htm

TRAINING PROGRAMS IN WASHINGTON STATE Ø Clinical Laboratory Science/Medical Technologist Heritage University Yakima Regional CLS Program Contact: Terese Abreu, M. A. , CLS (NCA), MT (ASCP) Phone: (509) 865 -8642 email: clinicallab@heritage. edu website: http: //www. heritage. edu Sacred Heart Medical Center Contact: Cynthia Hamby, MEd, MT(ASCP) Phone: (509) 474 -3339 email: hambyc@shmc. org website: http: //www. shmclab. org

TRAINING PROGRAMS IN WASHINGTON STATE Ø Clinical Laboratory Science/Medical Technologist University of Washington Contact: Mary Lampe, Ph. D Phone: (206) 598 -2135 email: lampe@u. washington. edu web site: http: //depts. washington. edu/labweb/Education/Med. Tec h/index. htm

TRAINING PROGRAMS IN WASHINGTON STATE Ø Clinical Laboratory Technician/Medical Laboratory Technician Clover Park Technical College Contact: Anne O'Neil, MT (ASCP) Phone: (253) 589 -5625 email: anne. oneil@cptc. edu website: http: //www. cptc. edu/wrl. asp? i. SRN=11021&t=wrl Renton Technical College Contact: Michael Sealfon, Ph. D Phone: (425) 235 -2352 Ext 2018 email: msealfon@rtc. edu website: http: //www. rtc. edu/programs/Training. Programs/Certifi ed. Medical. Lab. Tech/

TRAINING PROGRAMS IN WASHINGTON STATE Ø Clinical Laboratory Technician/Medical Laboratory Technician Shoreline Community College Contact: Molly Morse Phone: (206) 546 -6947 email: mmorse@shoreline. edu website: http: //www. shore. ctc. edu/shoreline/medlablocal. html Wenatchee Valley College Contact: Pamela Wilson-Mc. Namara Phone: (509) 682 -6668 email: pwilson-mcnamara@wvc. edu website: http: //www. wvc. edu/go/mlt

TRAINING PROGRAMS IN WASHINGTON STATE Ø Histotechnician Clover Park Technical College Contact: Rebecca Haggerty, HT (ASCP) Phone: (253) 589 -4526 Email: Bekki. Haggerty@cptc. edu Website: http: //www. cptc. edu/wrl. asp? i. SRN=11073&t=wrl

ADDITIONAL INFORMATION Ø Ø Visit www. naacls. org for a complete listing of accredited programs Other useful sites www. labcareers. org www. ascls. org www. nca-info. org www. labsarevital. com

BECOME A LABORATORY PROFESSIONAL TODAY! Photos are copyrighted. Please ask for permission before use. Clinicallab@heritage. edu
ba32a1c2907f2d2844be64e3b1bf5b04.ppt